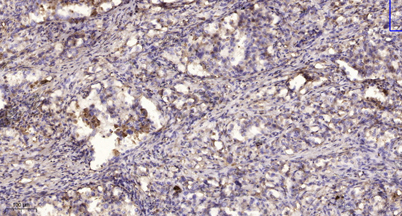

$148.00/50µL $248.00/100µL
| 50 µL | $148.00 |
| 100 µL | $248.00 |
| Product name: | Ribosomal Protein L11 rabbit pAb |
| Reactivity: | Human;Mouse;Rat |
| Alternative Names: | RPL11; 60S ribosomal protein L11; CLL-associated antigen KW-12 |
| Source: | Rabbit |
| Dilutions: | WB 1:500-2000;IHC-p 1:50-300; ELISA 2000-20000 |
| Immunogen: | Synthesized peptide derived from Ribosomal Protein L11 . at AA range: 100-180 |
| Storage: | -20°C/1 year |
| Clonality: | Polyclonal |
| Isotype: | IgG |
| Concentration: | 1 mg/ml |
| Observed Band: | 20kD |
| GeneID: | 6135 |
| Human Swiss-Prot No: | P62913 |
| Cellular localization: | Nucleus, nucleolus . Cytoplasm . |
| Background: | Ribosomes, the organelles that catalyze protein synthesis, consist of a small 40S subunit and a large 60S subunit. Together these subunits are composed of 4 RNA species and approximately 80 structurally distinct proteins. This gene encodes a ribosomal protein that is a component of the 60S subunit. The protein belongs to the L5P family of ribosomal proteins. It is located in the cytoplasm. The protein probably associates with the 5S rRNA. Alternatively spliced transcript variants encoding different isoforms have been found for this gene. As is typical for genes encoding ribosomal proteins, there are multiple processed pseudogenes of this gene dispersed through the genome. [provided by RefSeq, Dec 2010], |